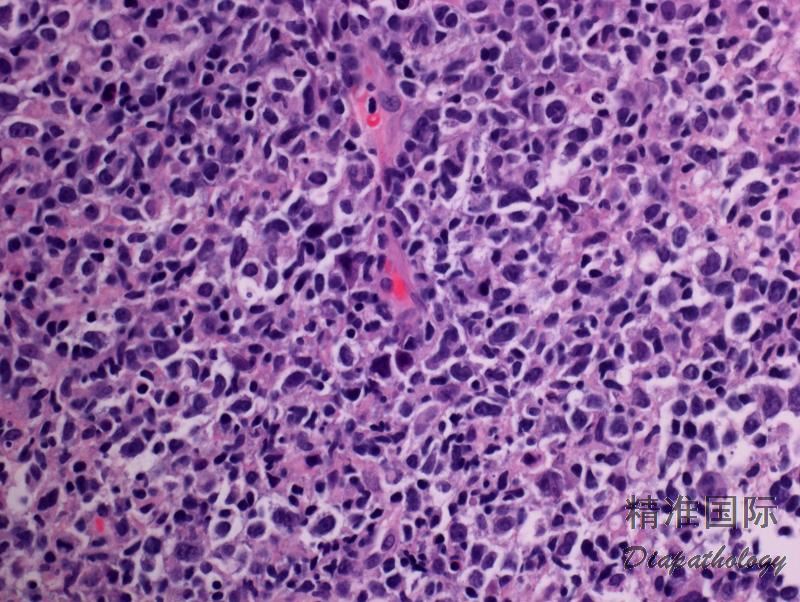
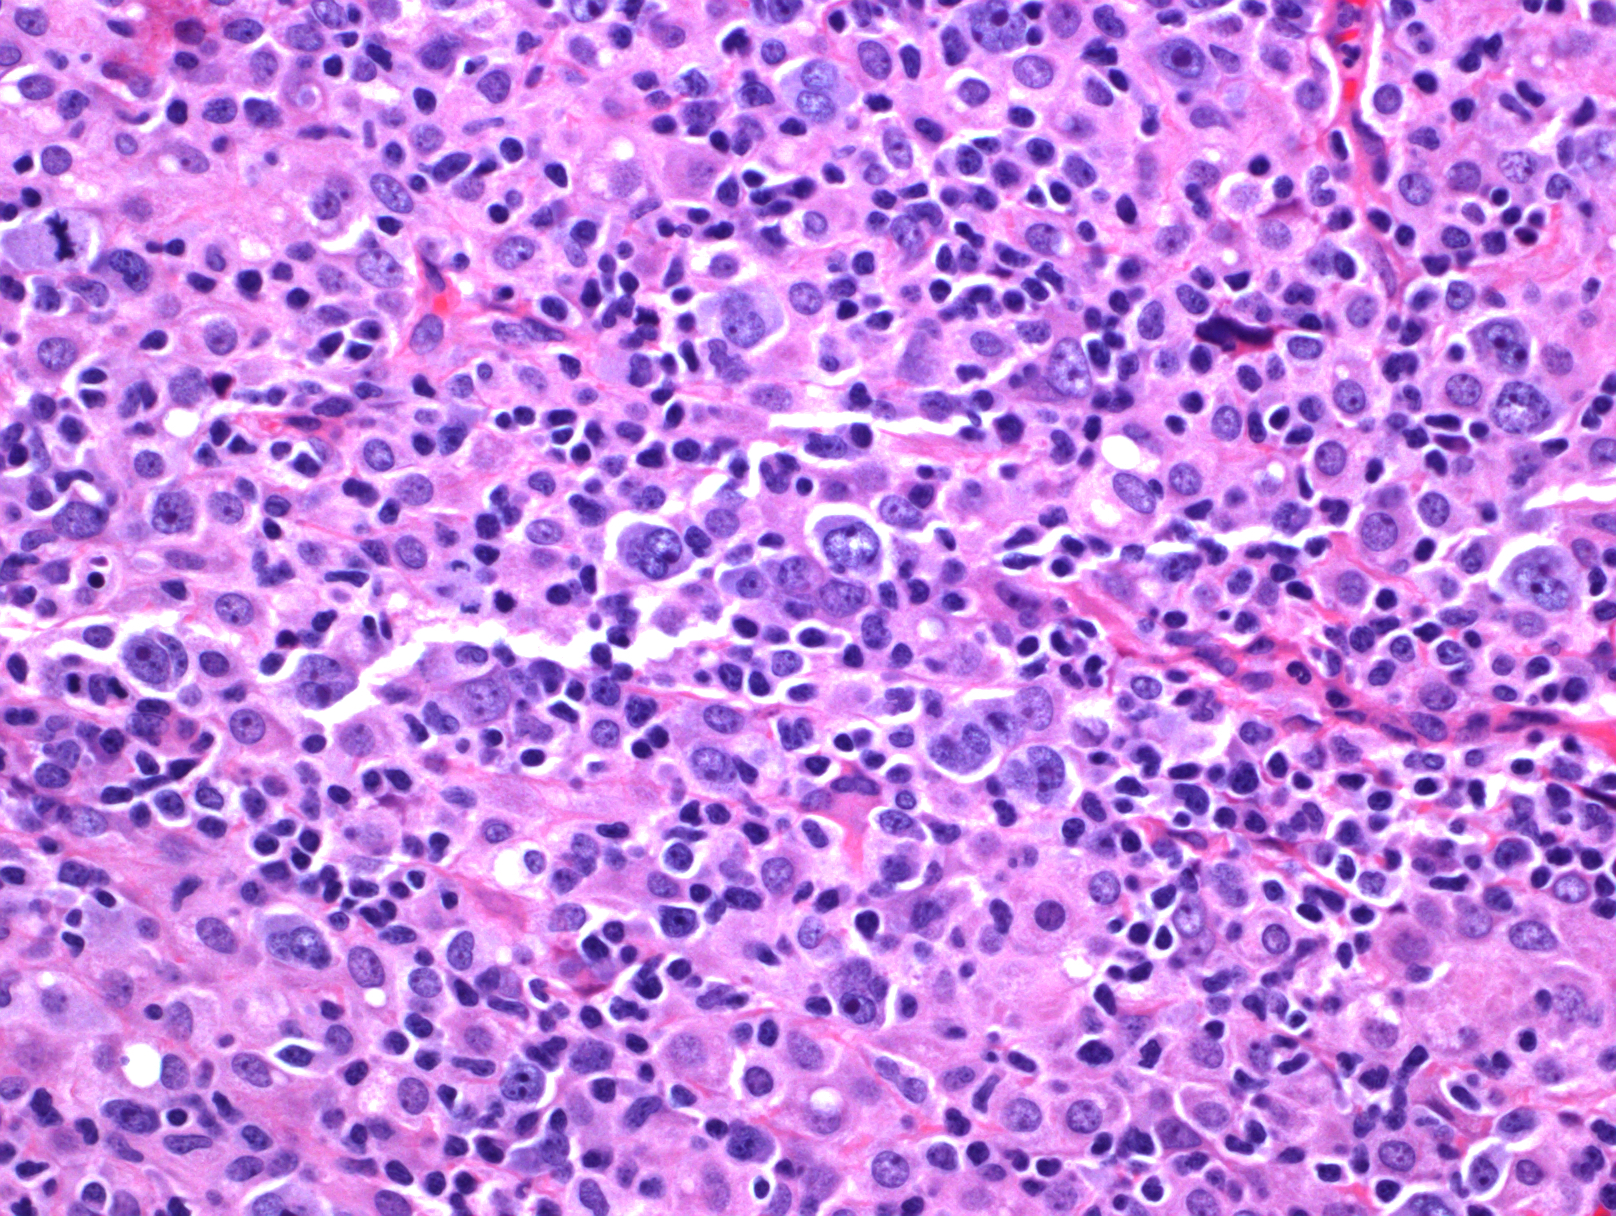
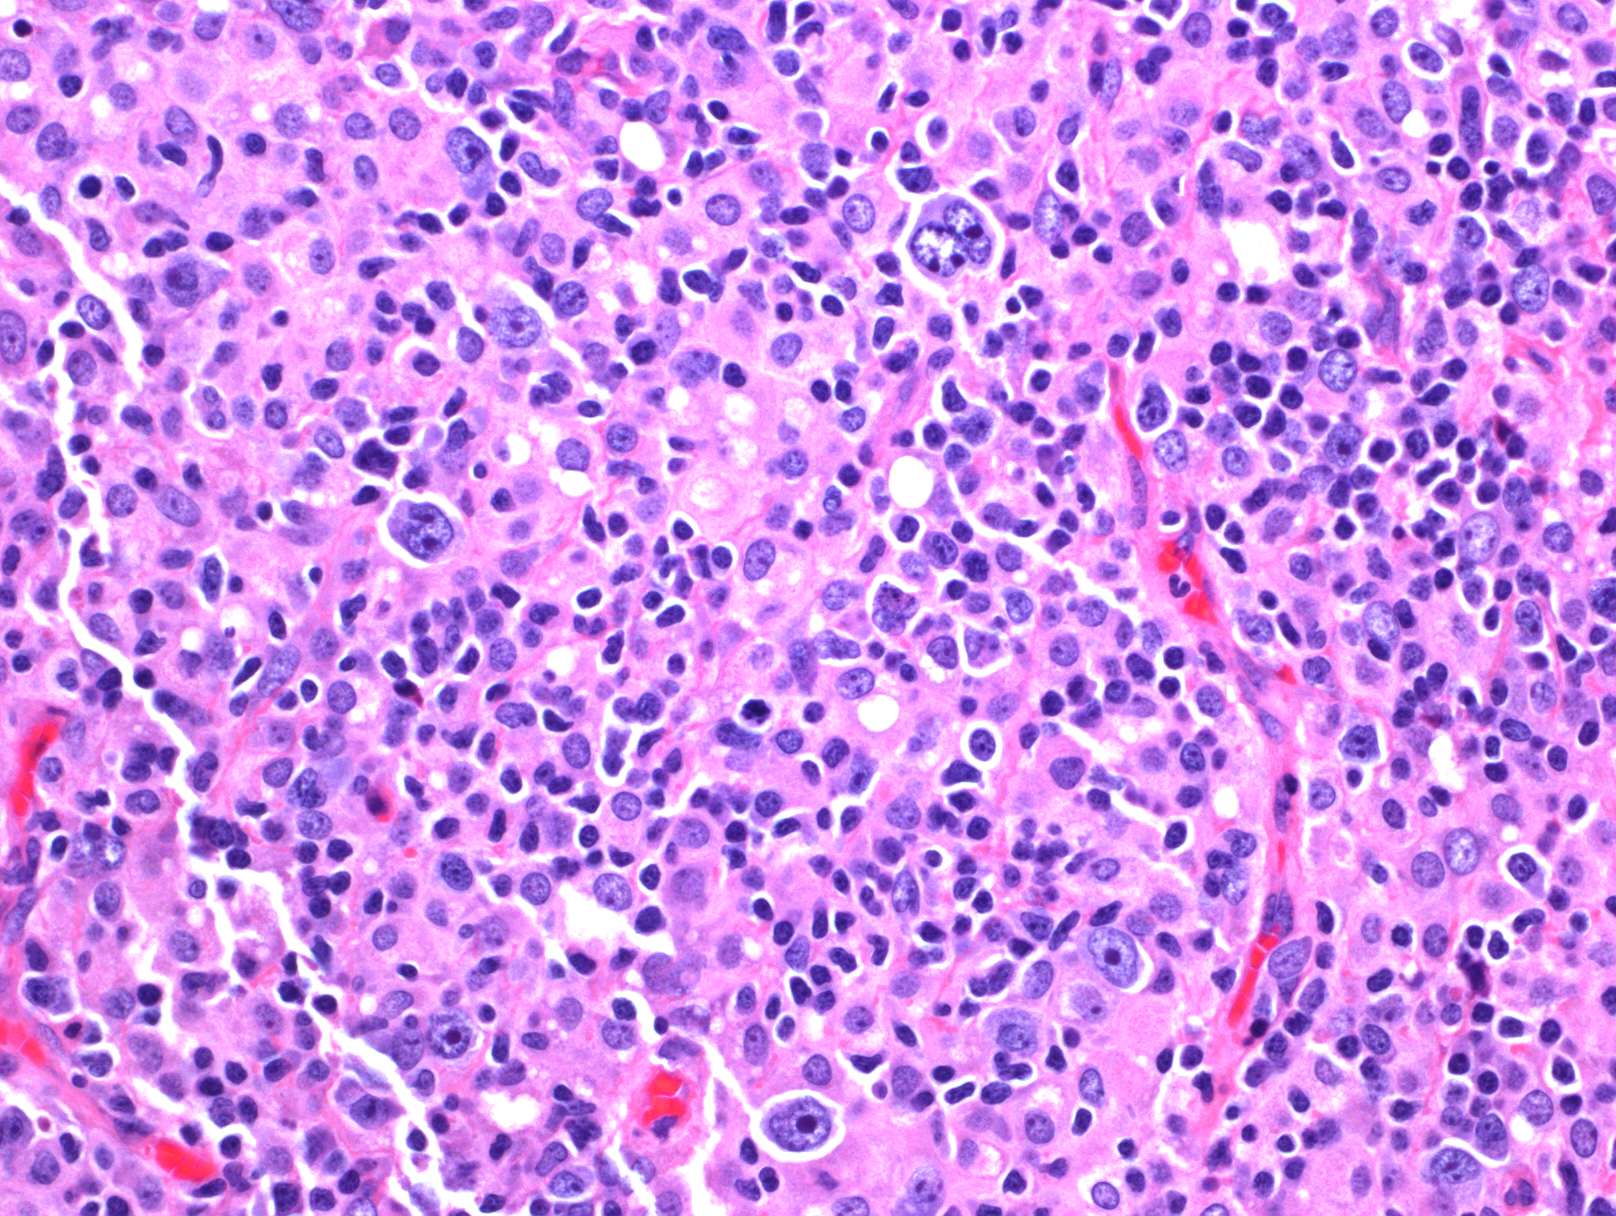

EBV 阳性弥漫大 B 细胞淋巴瘤,非特指型
EBV+ Diffuse Large B-Cell Lymphoma,NOS
概述:
EBV 感染引起的克隆性 B 细胞增生,多发生在 50 岁以上,但也见于年轻患者,无已知免疫缺陷或淋巴瘤病史,累及淋巴结(年轻患者)和结外组织(老年多见),临床表现为侵袭性,但年轻人预后较好。需除外其它 EBV 相关淋巴增生性疾病实体(如淋巴瘤样肉芽肿、急性或新近 EBV 感染、浆母细胞淋巴瘤等)。
发病部位: 最常见结外部位有淋巴结(年轻患者)和结外组织(老年患者)包括皮肤、肺、扁桃体等。
诊断要点:
- 老年发病中位年龄 70 岁,大多数(70%)表现为结外受累,伴或不伴淋巴结肿大,多为晚期,常有 B 症状;年轻人(< 45 岁)发病多累及淋巴结,临床预后较好。
- 肿瘤细胞弥漫浸润,正常组织或淋巴结结构完全破坏,常伴凝固性坏死。
- 肿瘤细胞型态类似中心母细胞、免疫母细胞,浆母细胞、Reed-Sternberg 样细胞或呈现多形性细胞。老年多累及结外组织,常表现两种形态亚型:(1)多形态亚型:肿瘤细胞中混有大量反应性细胞如小淋巴细胞、组织细胞和浆细胞;(2)大细胞亚型:成片大肿瘤细胞。年轻人多累及淋巴结,常表现为三种形态亚型:(1)T/组织细胞丰富型大 B 细胞淋巴瘤样;(2)灰区淋巴瘤样(介于典型霍奇金淋巴瘤和弥漫大 B 淋巴瘤之间);(3)弥漫大 B 淋巴瘤(非特指)样。以上亚型的确定虽有助诊断,但有一定主观随意性,不是必需的。
- 肿瘤细胞表达全 B 细胞抗原(CD20+、CD79a+、PAX5+、OCT+、BOB1+),偶尔 CD20 阴性(见于浆母细胞样病例),常表达 MUM-1 ;CD30 也常阳性,但 CD15 一般阴性(偶有阳性);CD10 和 Bcl-6 很少表达;可以有限制性轻链表达(见于浆细胞分化病例);Ki67 分裂指数高。
- 肿瘤细胞 EBER+ (占肿瘤细胞多数,常超过 80%)
- 无特征性的细胞遗传异常
- Ig 重链和轻链基因呈克隆性重排,并有 IgHV 重链基因体细胞超突变。

鉴别诊断:
- EBV+ 皮肤黏膜溃疡 (EBV+ mucutaneous ulcer): 中老年发病,常有免疫抑制史。表现为局限性黏膜溃疡,常见部位为口咽或肠道。组织学见多形性细胞和异型大细胞浸润,包括 HRS 样细胞,其免疫表型为 CD30+,CD15+/-,CD20+(有时较弱),EBRR+。背景可见大量小 T 细胞。部分病例 Ig 基因呈现克隆性重排,有的也有 TCR 基因克隆性或限制性重排。病变常自行消失,特别是去除免疫抑制因素后。故应首选保守治疗
- 经典型霍奇金淋巴瘤 (CHL):多形态亚型老年 EBV 阳性弥漫大 B 细胞淋巴瘤(伴 RS 样细胞时)容易与 CHL(混合细胞性)混淆。前者常发生在结外组织,呈地图样坏死,除 RS 样细胞外,常还有中间“多渡”型肿瘤细胞,RS 样细胞 CD15 一般阴性。CHL 很少发生在结外组织,除少量特征性的散在 HRS 细胞,无中间过渡型细胞,HRS 细胞 CD30+、CD15+、 CD20- 、LCA-;背景细胞常有噬酸性粒细胞或中性粒细胞。
- 弥漫性大 B 细胞淋巴瘤 (DLBCL):肿瘤大细胞成片,除表达全 B 抗原外,常表达 CD10 和 BCl-6,一般 EBV 阴性。
- 浆母细胞性淋巴瘤 (PBL):绝大多数患者有 HIV 感染病史。肿瘤细胞成片,呈浆母细胞样或免疫母细胞样形态,CD138+,CD79a+,MUM-1+,CD20- PAX5-,轻链限制性表达。
- 移植后淋巴细胞增生性疾病 (PTLD):形态学与老年 EBV 阳性弥漫大 B 细胞淋巴瘤相似,但有器官移植病史。
- 灰区淋巴瘤 (介于典型霍奇金淋巴瘤和弥漫大 B 淋巴瘤之间):需与年轻 EBV+ 弥漫大 B 淋巴瘤的其中一亚型相鉴别。灰区淋巴瘤多位于纵隔,EBV 阴性或少数细胞阳性。
- T/组织细胞丰富型大 B 细胞淋巴瘤 :需与年轻 EBV+ 弥漫大 B 淋巴瘤的其中一亚型相鉴别。T/组织细胞丰富型大 B 细胞淋巴瘤无中间过渡型细胞,其它炎性细胞少,且 EBV 阴性。
治疗:
尚无公认的治疗方案,一般用 CHOP。
